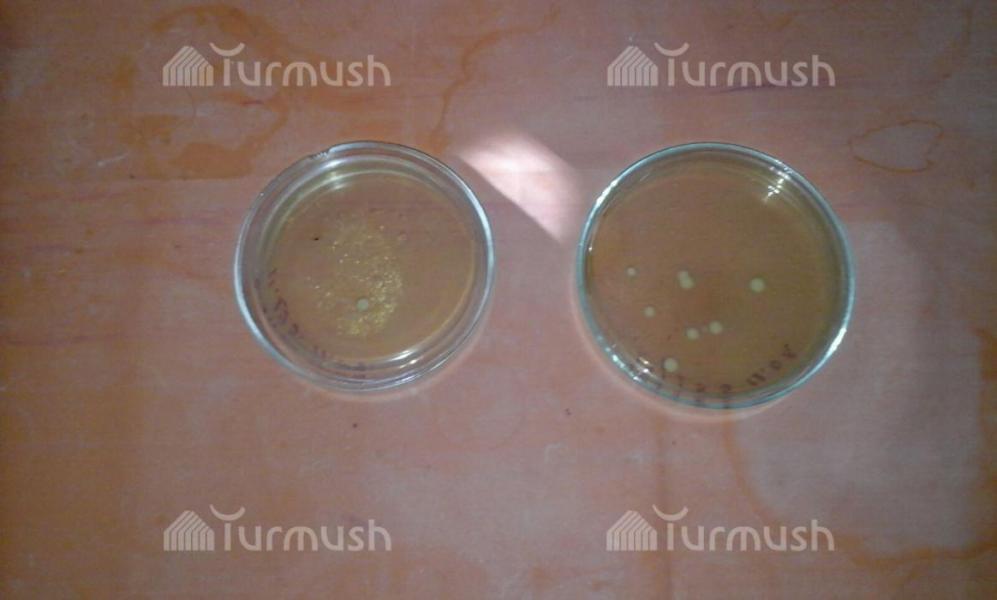

Полный доступ к архивам АКИpress (общественно-политические новости, культура, происшествия и спорт, а также новости стран ЦА)
1 новость950 сомКупить
год15000 сомподписаться?
Данные тарифы действуют только для частных лиц.
Если вам необходим корпоративный доступ к материалам (для организаций, госорганов, ведомств и т.д), пожалуйста, свяжитесь с нами по почте info@akipress.org
Если вам необходим корпоративный доступ к материалам (для организаций, госорганов, ведомств и т.д), пожалуйста, свяжитесь с нами по почте info@akipress.org